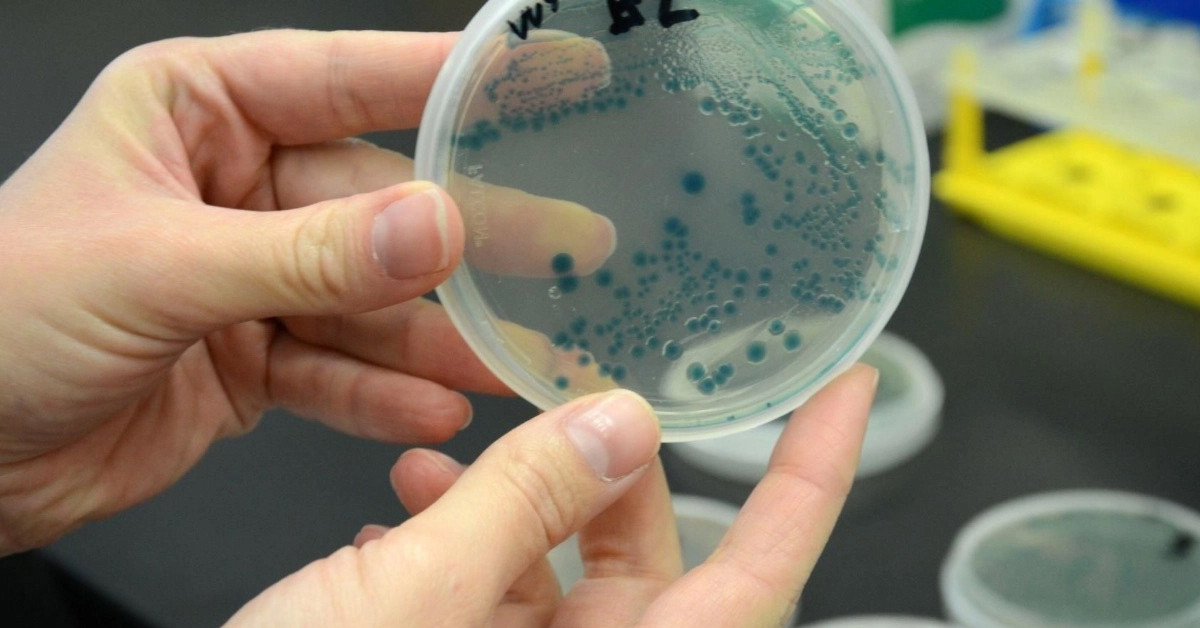

Güneş'e
01:23:25
İstanbul
0°
Şehir seçiniz
- Adana
- Adıyaman
- Afyonkarahisar
- Ağrı
- Amasya
- Ankara
- Antalya
- Artvin
- Aydın
- Balıkesir
- Bilecik
- Bingöl
- Bitlis
- Bolu
- Burdur
- Bursa
- Çanakkale
- Çankırı
- Çorum
- Denizli
- Diyarbakır
- Edirne
- Elazığ
- Erzincan
- Erzurum
- Eskişehir
- Gaziantep
- Giresun
- Gümüşhane
- Hakkari
- Hatay
- Isparta
- Mersin
- İstanbul
- İzmir
- Kars
- Kastamonu
- Kayseri
- Kırklareli
- Kırşehir
- Kocaeli
- Konya
- Kütahya
- Malatya
- Manisa
- Kahramanmaraş
- Mardin
- Muğla
- Muş
- Nevşehir
- Niğde
- Ordu
- Rize
- Sakarya
- Samsun
- Siirt
- Sinop
- Sivas
- Tekirdağ
- Tokat
- Trabzon
- Tunceli
- Şanlıurfa
- Uşak
- Van
- Yozgat
- Zonguldak
- Aksaray
- Bayburt
- Karaman
- Kırıkkale
- Batman
- Şırnak
- Bartın
- Ardahan
- Iğdır
- Yalova
- Karabük
- Kilis
- Osmaniye
- Düzce